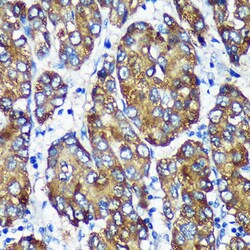
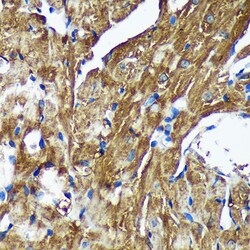

Learn More
Invitrogen™ NSDHL Polyclonal Antibody


Rabbit Polyclonal Antibody
Supplier: Invitrogen™ PA5116701
Description
Positive samples: 293T; Cellular location: endoplasmic reticulum, lipid droplet Immunogen sequence: MEPAVSEPMR DQVARTHLTE DTPKVNADIE KVNQNQAKRC TVIGGSGFLG QHMVEQLLAR GYAVNVFDIQ QGFDNPQVRF FLGDLCSRQD LYPALKGVNT VFHCASPPPS SNNKELFYRV NYIGTKNVIE TCKEAGVQKL ILTSSASVIF EGVDIKNGTE DLPYAMKPID YYTETKILQE RAVLGANDPE KNFLTTAIRP HGIFGPRDPQ LVPILIEAAR NGKMKFVIGN GKNLVDFTFV.
The protein encoded by this gene is localized in the endoplasmic reticulum and is involved in cholesterol biosynthesis. Mutations in this gene are associated with CHILD syndrome, which is a X-linked dominant disorder of lipid metabolism with disturbed cholesterol biosynthesis, and typically lethal in males. Alternatively spliced transcript variants with differing 5' UTR have been found for this gene.
Specifications
| NSDHL | |
| Polyclonal | |
| Unconjugated | |
| Nsdhl | |
| AI747449; bare patches; Bpa; H105E3; NAD(P) dependent steroid dehydrogenase-like; NAD(P)-dependent steroid dehydrogenase-like protein; Nsdhl; Protein H105e3; SDR31E1; short chain dehydrogenase/reductase family 31E, member 1; sterol-4-alpha-carboxylate 3-dehydrogenase, decarboxylating; Str; striated; XAP104 | |
| Rabbit | |
| Affinity Chromatography | |
| RUO | |
| 18194, 309262, 50814 | |
| -20°C, Avoid Freeze/Thaw Cycles | |
| Liquid |
| ELISA, Immunohistochemistry (Paraffin), Western Blot, Immunocytochemistry | |
| 2.36 mg/mL | |
| PBS with 50% glycerol and 0.01% thimerosal; pH 7.3 | |
| Q15738, Q5PPL3, Q9R1J0 | |
| Nsdhl | |
| Recombinant fusion protein containing a sequence corresponding to amino acids 1-240 of human NSDHL (NP_0570061). | |
| 100 μL | |
| Primary | |
| Human, Mouse, Rat | |
| Antibody | |
| IgG |
Your input is important to us. Please complete this form to provide feedback related to the content on this product.